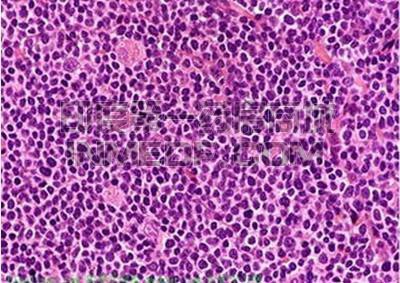
原发性纵隔大B细胞淋巴瘤

治疗原发性纵隔大B细胞淋巴瘤(PMBL)的药物
来源:网络收集 收录时间:2021-12-30热度: ℃
【资讯导读】 原发性纵隔大B细胞淋巴瘤(Primary mediastinal B-cell lymphoma,PMBL)是弥漫大B细胞淋巴瘤中的一个亚型,占B细胞淋巴瘤的10%左右,占纵隔肿瘤的1%-2%,临床表现主要为呼吸道症状,如
原发性纵隔大B细胞淋巴瘤(Primary mediastinal B-cell lymphoma,PMBL)是弥漫大B细胞
淋巴瘤中的一个亚型,占B细胞淋巴瘤的10%左右,占纵隔
肿瘤的1%-2%,临床表现主要为呼吸道症状,如:咳嗽、气促等。
治疗药物
如果原发性纵隔B细胞淋巴瘤复发或对化疗以及利妥昔单抗无效,则可以选择使用免疫治疗。
帕博利珠单抗(
可瑞达)是一种PD-(L)1
肿瘤免疫疗法,通过靶向阻断PD-1/PD-L1通路,利用人体自身的免疫系统对抗肿瘤,具有治疗多种类型肿瘤的潜力。
本站部分文章/图片收集于网络!如涉及版权请联系我们核实删除